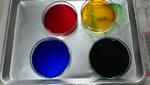

2月
令和8年2月27日(金)
3・4年生の書写の最終課題として、半紙を色で染めたうえに自分の好きな文字を書くという授業をしていました。色で染めた半紙も、一人一人模様や色合いが異なり、素敵でした。その上に一発勝負で文字を書く!その前に普通の半紙で練習するものの、緊張です。子どもたちが書いた文字、その作品は唯一無二の作品です。

令和8年2月24日(火)
来週の月曜日に実施予定の「6年生を送る会」に向けて、各学年の練習が進んでいます。体育館が空調工事のため使用できなかったのですが、今日から部分的に使用可能となり、当日の流れを練習しています。


また、本日は今年度最後の授業参観及び学級懇談会になります。6年生は小学校生活最後になります。学年でいろいろと企画しているようですので、お楽しみに!
令和8年2月19日(木)
5年生の特別授業が行われました。講師は、デフリンピック男子バレーボール日本代表監督の村井先生です。昨年東京でデフリンピックが開催されたので、記憶に新しいと思います。5年生は総合的な学習の時間に福祉について学んでいます。その際、デフリンピックに注目し、グループごとに調べ学習を進めました。大きなポスターにして学校の東校舎の各階廊下に掲示をし、他の学年も見られるようにしました。今日はその学習の発展として、デフバレーの監督にお話を聞きました。子どもたちは熱心に聞き、ワークシートは表だけでは足りず、裏面にもびっしりと書いている子が多かったです。印象的だったのは、デフリンピックのメンバーは耳が不自由なので目をみて話をすること、監督である自分が「伝える」ことより相手に「伝わったか」が大切なこと、デフスポーツの認知度を上げたいという願いなど、裏話も含めていろいろとお話していただきました。あっという間に時間が過ぎてしまいました。デフリンピックについての学びが、より深いものになった時間でした。村井先生ありがとうございました。ちなみに村井先生の出身は松戸市だそうです!





令和8年2月18日(水)
今日はクラブ活動最終日でした。クラブ活動は、4~6年生の縦割りの活動です。そして自分の興味関心のあるクラブで取り組みます。ただし、希望者数が多い場合は調整しています。運動系のクラブや文科系のクラブ、またPCを使うクラブ、将棋や囲碁などのゲームクラブもあります。今日は最終日だったので、1年間の振り返りと共に最後の活動を行いました。





令和8年2月16日(月)
2月・3月の給食の献立に、6年生が家庭科の授業で立てた献立を一部採用しています。今日は6年生が考えたメニューでした。「とり五目御飯」「ミネストローネスープ」「ナムル」「さばの塩焼き」「デコポン」「牛乳」です。今日のメニューのテーマは「万博」です。栄養や彩り、主菜・副菜のバランス、予算等を考えて立てています。クラスでプレゼンをして、選ばれたメニューが献立になります。
令和8年2月13日(金)
野菊野こども園の年長さんが学校見学に来ました。5年生が学校案内を含めた交流を実施しました。5年生とこども園の園児さんのうしろ姿を見ると、5年生が園児さんを気遣いながら活動している様子が伺えました。このような機会を積み重ねて、最高学年へとつながっていくのだと感じます。




5年生の算数の時間を見てきました。円の円周率について学習していました。いろいろな大きさの円形のものを実際に用意し、円の周りの長さを測り、直径も測り、円周率って本当に3.1くらいなのかどうかを確認していました。さすがに計算は電卓を活用しました。ただ単に円周率は3.14と覚えるのではなく、自分たちで確認することで、より確実に記憶に残ります。測ってみると、誤差も生じるので、すべてが「3.1415・・・」にはなりませんが、およそ3.1になることを確認できました。




令和8年2月12日(木)
5くみに特別支援学校のお子さんが交流で来校しました。来校に合わせて5くみでは「5くみまつり」を企画し準備をしてきました。今年は「いらいらぼう」と「輪投げ」「わにパニック」のコーナーを作りました。「いらいらぼう」は型に触らないように割り箸を動かすゲーム。輪投げはペットボトルバージョンと紙コップバージョンがありました。紙コップは難易度が高いです。そして「わにパニック」はもぐらたたきのようなゲームのわにバージョン。わには手作業で出てきます。それもまた楽しかったです。交流で来たお子さんも、子どもたちも、そして先生たちも楽しい時間を過ごしました。



令和8年2月10日(火)
6年生が「和名ヶ谷の魅力度をあげようプロジェクト」の活動で、スーパーのヤオコーさんにご協力いただき、イベントを実施しました。
子どもたちは、和名ヶ谷の美味しい野菜をもっと広めたいと考えました。スーパーのお客さんに声をかけ、クイズに挑戦していただき、結果により和名ヶ谷の「ねぎ」をプレゼントするという企画です。ヤオコーさんに企画を提案したり、学校HPで宣伝したり、賞品の「ねぎ」を和名ヶ谷の農家さんにお願いして準備したりと、活動してきました。ヤオコーの店長さんは、店内アナウンスでこの企画を紹介してくださいました。子どもたちのアイデアを形にしてくださり、ありがとうございます。クイズにご協力いただいたお客さんの皆さん、野菜を提供してくださった農家さん、場所を提供してくださったヤオコーさん、ありがとうございました。子どもたちの大きな学びとなりました。



令和8年2月6日(金)
6年生が理科の授業でプログラミングに挑戦していました。「発電と電気の利用」の単元です。暗くなると明かりが付く街灯や、人が近づくと動き始めるエスカレーターにもプログラミングがされています。子どもたちへの課題は、①ボタンが1回押されたら「ピアノのレ」の音が鳴る。②ボタンが1回押されたらLEDが点灯して「ピアノのミ」の音が鳴る。などの課題にチャレンジ。仕組みを理解すると、次々にクリアしていきました。クリアしたグループには更に追加のレベルアップ問題が用意されています。グループで試行錯誤しながら学んでいました。





令和8年2月5日(木)
今日は、ひまわり保育園の年長さんが学校見学に来ました。5年生が対応し、自己紹介やちょっとした遊び、そして学校を案内して回りました。4月に入学した後、今の5年生が6年生になった際に、関りが多くあるので、毎年5年生が担当しています。このような活動を通して、徐々に最高学年への意識を高めていくことと思います。表情はすっかりお兄さん、お姉さん。頼もしい姿が見られました。



4年生と3年生で総合的な学習の時間を進めていました。4年生が社会の時間と総合の時間を活用して「松戸市」について調べ、3年生を対象に調べたことを発表(PR)しました。調べたことを、よりわかりやすく発表するためにプレゼン資料も作成しました。3年生も、しっかりと聞き、クイズにもチャレンジしながら松戸市について学ぶことができました。





令和8年2月4日(水)
午後、校舎内を歩いていたら4年生が理科室で実験をしていました。また、4年生の別のクラスは校庭で体育の授業をしていました。4年生の様子をお伝えします。理科は「ものの温まり方」の学習で実験をしていました。ビーカーに入れた水をコンロにおいて火をつけて熱します。徐々に温度は上がりますが、水がどのように温まっていくのか、サーモインクというものを使用して可視化してみました。子どもたちは目に見えて動きが分かり、驚きの声をあげていました。

体育の授業では、サッカーに取り組んでいました。チームに分かれ、試合にチャレンジ。6チームあり、3コート作って試合をしていました。途中はわかりませんが、チームごとに自分たちの課題は何か考え、作戦を立てたり、練習したりしながら試合に繋げているのだと思います。最後はみんなで片づけまでしっかり行いました。



令和8年2月3日(火)
入学説明会を実施しました。この4月に入学する予定の保護者の方を対象に、本校の教育目標や、学校の様子についてお話しました。また、入学までに準備していただきたいもの、入学までにできるようになっていほしいことなどについてもお伝えしました。入学まで2か月です。不明な点は遠慮なくご連絡ください。職員一同、お子様の入学を心よりお待ちしております!
令和8年2月2日(月)
早いもので、2026年になって1か月が経ち、2月に入りました。今日は全校朝会でした。校長の話は「今年度も残り2か月なので、周りの人の良いところを見つけ、伝え合い・認め合いながら過ごしましょう。」と伝えました。この1年間が充実していたと思えるよう、残りの2か月をどう過ごすのかが大切だと思います。学習のまとめも必要ですが、よりよい人間関係を築いて、次の学年にステップアップしてほしいです。生活目標の話では、保健委員会が実験してつくった手洗いの映像を見て、感染症予防のためにしっかり石鹸で手を洗う重要性を理解したことと思います。
































